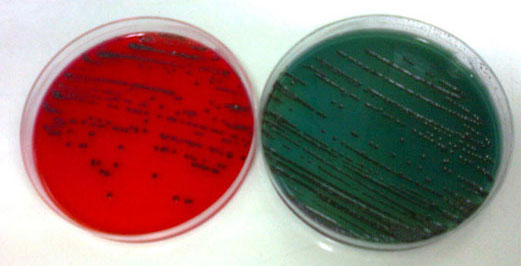

Microbiologie des Produits Alimentaires
Les analyses bactériologiques alimentaires sont indispensables pour vérifier la conformité des produits par rapport à la réglementation “hygiène” en vigueur. Elles doivent évaluer les flores pathogènes et d’altération présentes dans les aliments. En effet, ceux-ci sont rarement stériles et sont périodiquement contaminés de façon primaire ou lors des manipulations auxquelles ils sont soumis durant leur fabrication. Certains microorganismes ne posent pas de problème alors que d’autres peuvent être dangereux pour la santé humaine. Il s’agit donc soit de rechercher des contaminations par identification de microorganismes pathogènes et quantification du nombre de colonies, soit des germes témoins de mauvaises pratiques hygiéniques.
Les laboratoires de microbiologie du LCAE : Garant de Qualité
- Expérience de plus de 30 ans
- Disponibilité de cette activité au niveau des centres techniques de TUNIS, SFAX et SOUSSE du LCAE
- Accréditation du laboratoire de microbiologie des produits alimentaires et des eaux de TUNIS depuis 2004 (environ 17 ans), par le comité Francais d'Accréditation COFRAC puis le conseil National d’Accréditation TUNAC .
- Participation aux réseaux d’inter comparaisons : RAEMA depuis 2003 ; BIPEA depuis 2007 ; AGLAE : depuis 2012 ; PHE depuis 2017
- Surveillance régulière de la validité des résultats en appliquant un programme de contrôle interne tout au long de la réalisation des analyses.
Nature des Analyses :
- Les micro-organismes d’altérations
- Les micro-organismes indicateurs technologiques
- Les micro-organismes de contamination fécale
- Les micro-organismes pathogènes
- Contrôle de la stabilité des conserves
- Liste des analyses
Nature des Produits :
- les produits destinés à la consommation humaine ou à l’alimentation animale
- Les viandes fraîches, crues et transformées, les volailles et les gibiers, et leurs produits dérivés
- Produits de la pêche ; crustacés entiers ou décortiqués; céphalopodes; mollusques bivalves; gastéropodes & Produits transformés
- Les Céréales et produits céréaliers : produits de boulangerie, pâtisseries et gâteaux;
- Aliments pour animaux ;
- Margarines, produits à tartiner et produits non laitiers contenant de l’eau;
- Œufs et ovoproduits;
- Fruits et légumes frais et traités (surgelés, jus,…)
- Lait et produits laitiers dérivés
- Les produits appertisés et assimilés (conserves alimentaires à pH<4.5 et pH>4.5
- Lait UHT et Stérilisé
Nos Compétences :
- Laboratoire Accrédité TUNAC depuis 2004
- Numéro d’accréditation: 1-0002
- Portée d’accréditation: Annexe technique ou tunac.tn
- Essais d'inter comparaison : RAEMA - PHE- AGLAE